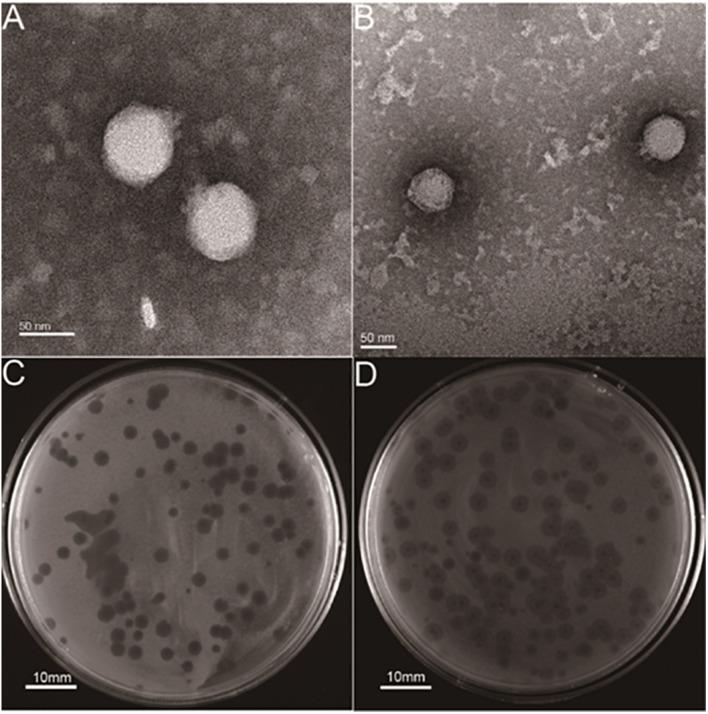
https://cdn.ncbi.nlm.nih.gov/pmc/blobs/da9a/8526901/710b1d8ee2be/fmicb-12-739319-g001.jpg

噬菌体选择压力通过基因的突变降低高毒力菌株的毒力。
Phage Selective Pressure Reduces Virulence of Hypervirulent Through Mutation of the Gene.
作者信息
Song Lingjie, Yang Xianggui, Huang Jinwei, Zhu Xiaokui, Han Guohui, Wan Yan, Xu Ying, Luan Guangxin, Jia Xu
机构信息
Non-coding RNA and Drug Discovery Key Laboratory of Sichuan Province, Chengdu Medical College, Chengdu, China.
Department of Laboratory Medicine, Clinical Medical College and the First Affiliated Hospital of Chengdu Medical College, Chengdu, China.
出版信息
Front Microbiol. 2021 Oct 6;12:739319. doi: 10.3389/fmicb.2021.739319. eCollection 2021.
Hypervirulent (hvKp), one of the major community-acquired pathogens, can cause invasive infections such as liver abscess. In recent years, bacteriophages have been used in the treatment of , but the characteristics of the phage-resistant bacteria produced in the process of phage therapy need to be evaluated. In this study, two Podoviridae phages, hvKpP1 and hvKpP2, were isolated and characterized. and experiments demonstrated that the virulence of the resistant bacteria was significantly reduced compared with that of the wild type. Comparative genomic analysis of monoclonal sequencing showed that nucleotide deletion mutations of and genes led to phage resistance, and the electron microscopy and mucoviscosity results showed that mutations led to the loss of the capsule. Meanwhile, animal assay indicated that loss of capsule reduced the virulence of hvKp. These findings contribute to a better understanding of bacteriophage therapy, which not only can kill bacteria directly but also can reduce the virulence of bacteria by phage screening.
高毒力肺炎克雷伯菌(hvKp)是主要的社区获得性病原体之一,可引起侵袭性感染,如肝脓肿。近年来,噬菌体已被用于治疗,但噬菌体治疗过程中产生的噬菌体抗性细菌的特性需要评估。在本研究中,分离并鉴定了两种短尾噬菌体科噬菌体hvKpP1和hvKpP2。实验证明,与野生型相比,抗性细菌的毒力显著降低。单克隆测序的比较基因组分析表明,和基因的核苷酸缺失突变导致噬菌体抗性,电子显微镜和黏液粘度结果表明,突变导致荚膜丧失。同时,动物试验表明,荚膜丧失降低了hvKp的毒力。这些发现有助于更好地理解噬菌体治疗,其不仅可以直接杀死细菌,还可以通过噬菌体筛选降低细菌的毒力。